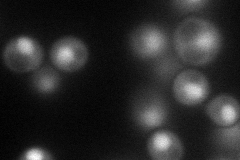
YML102W
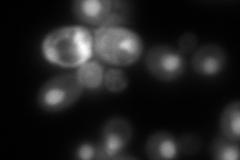
YML102W

View description
Component of the chromatin assembly complex (with Rlf2p and Msi1p) that assembles newly synthesized histones onto recently replicated DNA, required for building functional kinetochores, conserved from yeast to humans
Localization:
Intensity:
Fold change:
Significance:
-
C’ GFP library in SD

nucleus27.1 -
N' NOP1pr-GFP in SD
nucleus77.8301 -
N' TEF2pr-mCherry in SD
nucleus12.356 -
N' NATIVEpr-GFP in SD

nucleus23.5474 -
N' TEF2pr-VC and Cyto-VN in SD

#N/A0 -
C’ GFP library in SD+DTT

nucleus31.441.16No -
C’ GFP library in SD+H2O2

nucleus28.791.06No -
C’ GFP library in Starvation Media

nucleus23.510.86No -
C’ GFP library on the background of Pup2-DaMP

nucleus -
C’ GFP library on the background of CCT mutant

nucleus30.79611.13609No
